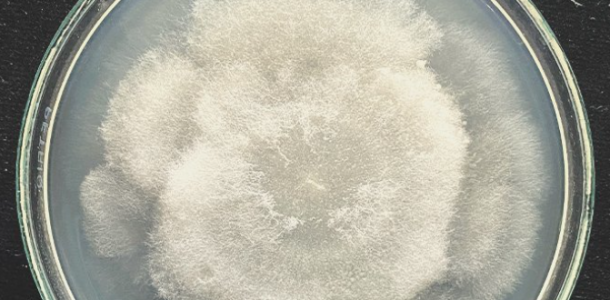
1646845347061.png 1646845347061.png

- 24 Апр 2020
- 7,333
- 14,763
-

- 6
Питиум — это коварный грибок, который представляет серьезную угрозу для корней конопли как в закрытых помещениях, так и под открытым небом. Этот микроскопический вредитель работает скрытно: сначала поражает корневую систему, а затем быстро разрушает ее, превращая когда-то крепкие белые корни в мягкую, зловонную буро-коричневую массу. Как результат — растение перестает получать воду и питательные вещества, теряет силы и в конечном итоге просто погибает. Все усилия гровера, часы ухода и заботы, вложенные в выращивание, оказываются напрасными.
Чтобы не допустить такой неприятности в своем саду, важно вовремя распознать проблему и знать, как с ней бороться. В этом материале мы подробно расскажем, что собой представляет питиум, как вовремя его обнаружить, какими способами можно эффективно устранить заражение и какие профилактические меры помогут предотвратить его появление в будущем. Если внимательно изучить все советы и применять их на практике, риск столкнуться с этой напастью будет сведен к минимуму. Каннабис будет расти здоровым и сильным, а урожай — радовать количеством и качеством.
Что такое питиум или питиозная корневая гниль?
Среди гроверов термин «питиум» (Pythium) чаще всего звучит как приговор — именно его называют «корневой гнилью». Этот паразитирующий микроорганизм, относящийся к группе водных грибков, безжалостно атакует корневую зону растений. Особенно он любит влагу — любая чрезмерно увлажненная среда, будь то почва, кокос или гидропонный раствор, может стать для него идеальной ареной для размножения и заражения. Питиум особенно опасен для молодых организмов: семена, проростки и молодые саженцы оказываются под угрозой в первую очередь. Но не стоит думать, что взрослые растения в безопасности — если условия способствуют развитию грибка, он с легкостью атакует куст конопли на любой стадии развития, от вегетации до цветения.
Хорошая новость заключается в том, что с этим заболеванием можно справиться. Более того, при должном внимании и уходе — его и вовсе можно избежать. Профилактика здесь играет решающую роль. Правильный режим полива, контроль температуры и влажности, хорошая вентиляция и чистота в гроуруме позволяют на 99% защититься от этой заразы. Но даже если беда все-таки случилась — это еще не конец. При своевременном обнаружении и принятии мер у растения есть шанс выжить и восстановиться.
Важно понимать, что питиум — не тот враг, которого можно распознать сразу. Он действует втайне, из-под земли, и в большинстве случаев гровер замечает проблему только тогда, когда внешние признаки становятся очевидными. К их числу относятся:
Обнаружить питиум в саду, где растет каннабис, — это неприятно, неожиданно и больно. И не важно, выращиваете ли кусты на свежем воздухе или предпочитаете домашние тепличные условия — опасность подстерегает всех. Даже если вы используете только проверенный, покупной грунт высокого качества, нет стопроцентной гарантии, что споры этого грибка не затаились где-то внутри него, ожидая благоприятного момента для атаки. Особенно сложно заметить питиум при выращивании в земле или в субстратах вроде кокосового волокна и минеральной ваты. Здесь он скрывается в толще среды и работает втайне, подрывая здоровье растения. В гидропонных же системах, где корни плавают в питательном растворе и часто остаются на виду, заметить проблему становится немного проще. Но есть нюанс: это касается в основном активных систем, где жидкость циркулирует постоянно. В пассивных решениях вроде «конопляного ведра» или капельных систем доступ к корням ограничен, так что визуальный контроль становится почти невозможным.
Основной симптом, на который стоит обращать внимание в первую очередь — это изменение внешнего вида корневой системы. Вместо здоровых белых корней вы увидите неприятную картину: коричневые, вялые и рыхлые корни, окруженные мутной слизистой массой. Как говорят учебники по ботанике, в 9 случаях из 10 при такой картине виновником будет именно питиум. И для многих гроверов это момент настоящего ужаса: увидеть, как твои старания превращаются в кашу под ногами, — зрелище не для слабонервных.
Кроме явных изменений внешнего вида, питиум выдает себя еще и характерным запахом. Если при осмотре корней или субстрата вы уловили тухлый аромат гнили, напоминающий старую плесень или разложение, — это верный тревожный звоночек. Но дело осложняется тем, что надземная часть растения тоже начинает подавать сигналы бедствия, причем эти симптомы легко спутать с другими распространенными проблемами. Кусты начинают выглядеть подавленно: листья скручиваются, увядают, опадают, теряют свою яркую окраску. Иногда зелень становится почти белой или желтой, иногда на ней появляются пятна — бурые, коричневые, ржавые. Всё это легко можно принять за последствия перекорма удобрениями, ожога от лампы или температурного стресса. Из-за этого многие новички и даже опытные гроверы ошибочно лечат совсем не ту проблему, теряя драгоценное время.
Важно помнить: любое необычное пожелтение листьев должно настораживать, особенно если оно сопровождается вялостью и остановкой роста. Лучше потратить несколько минут на тщательную проверку корней, чем потом сожалеть о потерянном урожае.
Создание идеальных условий для проращивания и высадки семян конопли — это прочный фундамент для будущего урожая. Без него все остальное просто теряет смысл, ведь если семечко не раскроется и не начнет рости, то и мечтать о жирных шишках нет смысла. Во время вегетативного этапа, особенно когда приходит время пересаживать кусты, конопля становятся уязвимой как никогда. Независимо от того, где вы ее растите — в земле, кокосе или гидропонике — пересадка всегда риск. В этот момент растение может словить стресс или подхватить какую-нибудь болячку. Поэтому гровер должен быть начеку и действовать аккуратно: стараться минимизировать повреждения корней и сразу после пересадки предоставить каннабису максимально комфортные условия — нормальное питание, правильную температуру и влажность воздуха.
Еще очень важно помнить, что грибок питиум обожает сырые места. Если корни постоянно мокрые, шанс нарваться на эту гадость резко увеличивается. Поэтому золотое правило — поливать только тогда, когда грунт действительно подсох. Постоянное болото в горшке — это не забота о растении, а прямая дорога к проблемам. Настроить грамотный цикл «полив-засуха» — лучшее, что можно сделать для здоровья корневой системы.
Те, кто растит коноплю в гидропонике, тоже в зоне риска. Им нужно следить за тем, чтобы вода в системе была хорошо насыщена кислородом. Во-первых, растения будут лучше усваивать питание, а во-вторых, в кислородной среде питиуму просто не выжить. Поэтому хороший воздушный насос — это не роскошь, а необходимость. И еще один важный момент: температура воды должна быть около комнатной. Теплая, застоявшаяся вода — идеальная среда для размножения грибка.
Отдельно стоит упомянуть воздушные горшки. Эти штуки классно работают как в классическом ручном поливе, так и в автоматических системах. Они помогают корням дышать и сами по себе делают горшок менее привлекательным для грибка. Да, стоят они дороже обычных пластиковых, но зато способны сэкономить нервы в будущем.
Ну и чтобы в общем и целом укрепить здоровье корней, гроверы часто добавляют в подкормку полезные микроорганизмы. Сейчас в магазинах и на гроверских сайтах можно найти кучу разных добавок, например, микоризы или жидкие ферменты. Некоторые из них стоят немало, но даже простые и недорогие варианты реально помогают. Потратиться немного в начале — потом с радостью собирать урожай в конце.
Устранение питиозной гнили у конопли
Когда заходит разговор про борьбу с питиозной гнилью в саду гровера, тут, как говорится, есть и хорошие, и плохие новости. Хорошая новость — грибок питиум можно реально вылечить и победить. Плохая — это удовольствие не из дешевых. На рынке полно всяких спецсредств против корневой гнили, но если смотреть по-честному, реально работающие штуки стоят прилично. И даже с ними результат на 100% можно ожидать только в индоре, и то на ранних стадиях, пока кусты еще на веге и не ушли в цветение.
Самый радикальный, но самый надежный способ — это, так сказать, нажать на «красную кнопку». То есть полностью остановить гров, тщательно продезинфицировать все оборудование, инструменты и само помещение, а после начинать все с чистого листа. Да, звучит жестко, но если питиум активничает не на шутку, лучше не тянуть и сразу включать режим экстренного реагирования. Борьба с этой гнилью — это настоящая война на истощение. Даже если победить, последствия будут. Грибок в любом случае подпортит растения: рост замедлится, здоровье пошатнется, и кустам понадобится время, чтобы прийти в себя. Особенно обидно, если проблема случится с автоцветами или в период цветения — тут уж никуда не деться, урожай точно пострадает.
Так что золотое правило: всегда легче предотвратить болезнь, чем потом с ней бороться. И питиум — не исключение.
Сорта конопли с защитой от грибков
Когда дело доходит до выбора сорта конопли для выращивания, особенно если у тебя были или есть проблемы с грибками вроде питиума, стоит подумать не только о вкусе и силе эффекта, но и о выносливости растения. Сорта с хорошей природной защитой от болезней и патогенов могут реально сэкономить гроверу кучу нервов, времени и денег. Такие растения проще выращивать, они меньше подвержены гнили, плесени и прочим неприятностям. Конечно, это не отменяет правил гигиены и ухода, но устойчивый генетический фундамент всегда дает фору в борьбе за здоровье сада.
В этой подборке мы собрали несколько проверенных сортов конопли, которые славятся своим крепким иммунитетом и неплохо справляются с грибковыми атаками. С ними шансов довести гров до счастливого и обильного финала будет намного больше.
Сорт конопли Kalashnikova от компании Green House Seeds – это результат скрещивания легендарного AK-47 и не менее легендарного White Widow. Такая родословная подарила канна-индустрии устойчивый и продуктивный гибрид, прекрасно подходящий как для опытных, так и для начинающих гроверов. Кусты среднего размера развиваются стремительно, формируя массивные шишки с толстым слоем смолы. В закрытом грунте растение готово к харвесту уже через 8 недель цветения. Урожайность составляет 750 грамм с одного квадратного метра в помещении и 1000 грамм со зрелого куста на улице. Вкусоароматические свойства Kalashnikova сочетают пряные, землистые и цитрусовые нотки. Содержание ТГК в 21% обеспечивает сбалансированное воздействие, сочетающее бодрящее, эйфорическое начало с глубоким, расслабляющим финишем. Каннабис отлично подходит как для дневного, так и для вечернего использования, а также обладает выраженными медицинскими свойствами, помогая бороться со стрессом, тревожностью и болевым синдромом.
Сорт конопли Peyote Critical от голландского сидбанка Barney's Farm – это стабильный индика-доминантный гибрид, в котором соединились гены Peyote Purple и Critical Kush. Благодаря такому сочетанию растение получило в наследство высокую урожайность, крепкий иммунитет к болезням и яркое психоактивное воздействие. Его кусты вырастают компактными и ветвистыми, достигая максимальной высоты в 100-180 см. Цветение длится 50-60 дней, а итоговая урожайность достигает 500-600 грамм с 1 м2 в помещении и 800 грамм с куста под открытым небом. Дегустация готового продукта порадует насыщенным ароматом древесины и кофейным вкусом со сладкими нотами. Воздействие дарит глубокий stone эффект, накрывающий мощной волной расслабления с легким психоделическим оттенком. Отличный выбор для вечернего отдыха, медитации или творческой деятельности.
Каннабис Auto Alpujarrena от сидбанка Pyramid Seeds представляет собой автоцветущую версию знаменитого одноименного растения, адаптированную для быстрого роста. Он отлично подходит для выращивания в суровых климатических условиях, так как спокойно переносит низкие температуры и перепады влажности. В помещении растишка тоже будет чувствовать себя комфортно, прекрасно реагируя на техники по контролю роста и увеличению урожайности. По строению кусты выделяются красивыми темно-зелеными листьями, средними междоузлиями, прочной центральной колой и плотными соцветиями, пропитанными насыщенным ароматом тропических фруктов. Во время дегустации ощущается приятный ягодный вкус, а также мощное расслабляющее воздействие, за считанные минуты снимающее усталость и нервное напряжение.
Чтобы не допустить такой неприятности в своем саду, важно вовремя распознать проблему и знать, как с ней бороться. В этом материале мы подробно расскажем, что собой представляет питиум, как вовремя его обнаружить, какими способами можно эффективно устранить заражение и какие профилактические меры помогут предотвратить его появление в будущем. Если внимательно изучить все советы и применять их на практике, риск столкнуться с этой напастью будет сведен к минимуму. Каннабис будет расти здоровым и сильным, а урожай — радовать количеством и качеством.
Что такое питиум или питиозная корневая гниль?
Хорошая новость заключается в том, что с этим заболеванием можно справиться. Более того, при должном внимании и уходе — его и вовсе можно избежать. Профилактика здесь играет решающую роль. Правильный режим полива, контроль температуры и влажности, хорошая вентиляция и чистота в гроуруме позволяют на 99% защититься от этой заразы. Но даже если беда все-таки случилась — это еще не конец. При своевременном обнаружении и принятии мер у растения есть шанс выжить и восстановиться.
Важно понимать, что питиум — не тот враг, которого можно распознать сразу. Он действует втайне, из-под земли, и в большинстве случаев гровер замечает проблему только тогда, когда внешние признаки становятся очевидными. К их числу относятся:
- замедление роста растения;
- вялость листьев и куста в целом;
- обесцвечивание листвы.
Обнаружить питиум в саду, где растет каннабис, — это неприятно, неожиданно и больно. И не важно, выращиваете ли кусты на свежем воздухе или предпочитаете домашние тепличные условия — опасность подстерегает всех. Даже если вы используете только проверенный, покупной грунт высокого качества, нет стопроцентной гарантии, что споры этого грибка не затаились где-то внутри него, ожидая благоприятного момента для атаки. Особенно сложно заметить питиум при выращивании в земле или в субстратах вроде кокосового волокна и минеральной ваты. Здесь он скрывается в толще среды и работает втайне, подрывая здоровье растения. В гидропонных же системах, где корни плавают в питательном растворе и часто остаются на виду, заметить проблему становится немного проще. Но есть нюанс: это касается в основном активных систем, где жидкость циркулирует постоянно. В пассивных решениях вроде «конопляного ведра» или капельных систем доступ к корням ограничен, так что визуальный контроль становится почти невозможным.
Основной симптом, на который стоит обращать внимание в первую очередь — это изменение внешнего вида корневой системы. Вместо здоровых белых корней вы увидите неприятную картину: коричневые, вялые и рыхлые корни, окруженные мутной слизистой массой. Как говорят учебники по ботанике, в 9 случаях из 10 при такой картине виновником будет именно питиум. И для многих гроверов это момент настоящего ужаса: увидеть, как твои старания превращаются в кашу под ногами, — зрелище не для слабонервных.
Кроме явных изменений внешнего вида, питиум выдает себя еще и характерным запахом. Если при осмотре корней или субстрата вы уловили тухлый аромат гнили, напоминающий старую плесень или разложение, — это верный тревожный звоночек. Но дело осложняется тем, что надземная часть растения тоже начинает подавать сигналы бедствия, причем эти симптомы легко спутать с другими распространенными проблемами. Кусты начинают выглядеть подавленно: листья скручиваются, увядают, опадают, теряют свою яркую окраску. Иногда зелень становится почти белой или желтой, иногда на ней появляются пятна — бурые, коричневые, ржавые. Всё это легко можно принять за последствия перекорма удобрениями, ожога от лампы или температурного стресса. Из-за этого многие новички и даже опытные гроверы ошибочно лечат совсем не ту проблему, теряя драгоценное время.
Важно помнить: любое необычное пожелтение листьев должно настораживать, особенно если оно сопровождается вялостью и остановкой роста. Лучше потратить несколько минут на тщательную проверку корней, чем потом сожалеть о потерянном урожае.
Создание идеальных условий для проращивания и высадки семян конопли — это прочный фундамент для будущего урожая. Без него все остальное просто теряет смысл, ведь если семечко не раскроется и не начнет рости, то и мечтать о жирных шишках нет смысла. Во время вегетативного этапа, особенно когда приходит время пересаживать кусты, конопля становятся уязвимой как никогда. Независимо от того, где вы ее растите — в земле, кокосе или гидропонике — пересадка всегда риск. В этот момент растение может словить стресс или подхватить какую-нибудь болячку. Поэтому гровер должен быть начеку и действовать аккуратно: стараться минимизировать повреждения корней и сразу после пересадки предоставить каннабису максимально комфортные условия — нормальное питание, правильную температуру и влажность воздуха.
Еще очень важно помнить, что грибок питиум обожает сырые места. Если корни постоянно мокрые, шанс нарваться на эту гадость резко увеличивается. Поэтому золотое правило — поливать только тогда, когда грунт действительно подсох. Постоянное болото в горшке — это не забота о растении, а прямая дорога к проблемам. Настроить грамотный цикл «полив-засуха» — лучшее, что можно сделать для здоровья корневой системы.
Те, кто растит коноплю в гидропонике, тоже в зоне риска. Им нужно следить за тем, чтобы вода в системе была хорошо насыщена кислородом. Во-первых, растения будут лучше усваивать питание, а во-вторых, в кислородной среде питиуму просто не выжить. Поэтому хороший воздушный насос — это не роскошь, а необходимость. И еще один важный момент: температура воды должна быть около комнатной. Теплая, застоявшаяся вода — идеальная среда для размножения грибка.
Отдельно стоит упомянуть воздушные горшки. Эти штуки классно работают как в классическом ручном поливе, так и в автоматических системах. Они помогают корням дышать и сами по себе делают горшок менее привлекательным для грибка. Да, стоят они дороже обычных пластиковых, но зато способны сэкономить нервы в будущем.
Ну и чтобы в общем и целом укрепить здоровье корней, гроверы часто добавляют в подкормку полезные микроорганизмы. Сейчас в магазинах и на гроверских сайтах можно найти кучу разных добавок, например, микоризы или жидкие ферменты. Некоторые из них стоят немало, но даже простые и недорогие варианты реально помогают. Потратиться немного в начале — потом с радостью собирать урожай в конце.
Устранение питиозной гнили у конопли
Самый радикальный, но самый надежный способ — это, так сказать, нажать на «красную кнопку». То есть полностью остановить гров, тщательно продезинфицировать все оборудование, инструменты и само помещение, а после начинать все с чистого листа. Да, звучит жестко, но если питиум активничает не на шутку, лучше не тянуть и сразу включать режим экстренного реагирования. Борьба с этой гнилью — это настоящая война на истощение. Даже если победить, последствия будут. Грибок в любом случае подпортит растения: рост замедлится, здоровье пошатнется, и кустам понадобится время, чтобы прийти в себя. Особенно обидно, если проблема случится с автоцветами или в период цветения — тут уж никуда не деться, урожай точно пострадает.
Так что золотое правило: всегда легче предотвратить болезнь, чем потом с ней бороться. И питиум — не исключение.
Сорта конопли с защитой от грибков
В этой подборке мы собрали несколько проверенных сортов конопли, которые славятся своим крепким иммунитетом и неплохо справляются с грибковыми атаками. С ними шансов довести гров до счастливого и обильного финала будет намного больше.
Сорт конопли Kalashnikova от Green House Seeds
Сорт конопли Kalashnikova от компании Green House Seeds – это результат скрещивания легендарного AK-47 и не менее легендарного White Widow. Такая родословная подарила канна-индустрии устойчивый и продуктивный гибрид, прекрасно подходящий как для опытных, так и для начинающих гроверов. Кусты среднего размера развиваются стремительно, формируя массивные шишки с толстым слоем смолы. В закрытом грунте растение готово к харвесту уже через 8 недель цветения. Урожайность составляет 750 грамм с одного квадратного метра в помещении и 1000 грамм со зрелого куста на улице. Вкусоароматические свойства Kalashnikova сочетают пряные, землистые и цитрусовые нотки. Содержание ТГК в 21% обеспечивает сбалансированное воздействие, сочетающее бодрящее, эйфорическое начало с глубоким, расслабляющим финишем. Каннабис отлично подходит как для дневного, так и для вечернего использования, а также обладает выраженными медицинскими свойствами, помогая бороться со стрессом, тревожностью и болевым синдромом.
Сорт каннабиса Peyote Critical от Barney's Farm
Сорт конопли Peyote Critical от голландского сидбанка Barney's Farm – это стабильный индика-доминантный гибрид, в котором соединились гены Peyote Purple и Critical Kush. Благодаря такому сочетанию растение получило в наследство высокую урожайность, крепкий иммунитет к болезням и яркое психоактивное воздействие. Его кусты вырастают компактными и ветвистыми, достигая максимальной высоты в 100-180 см. Цветение длится 50-60 дней, а итоговая урожайность достигает 500-600 грамм с 1 м2 в помещении и 800 грамм с куста под открытым небом. Дегустация готового продукта порадует насыщенным ароматом древесины и кофейным вкусом со сладкими нотами. Воздействие дарит глубокий stone эффект, накрывающий мощной волной расслабления с легким психоделическим оттенком. Отличный выбор для вечернего отдыха, медитации или творческой деятельности.
Сорт марихуаны Auto Alpujarrena от Pyramid Seeds
Каннабис Auto Alpujarrena от сидбанка Pyramid Seeds представляет собой автоцветущую версию знаменитого одноименного растения, адаптированную для быстрого роста. Он отлично подходит для выращивания в суровых климатических условиях, так как спокойно переносит низкие температуры и перепады влажности. В помещении растишка тоже будет чувствовать себя комфортно, прекрасно реагируя на техники по контролю роста и увеличению урожайности. По строению кусты выделяются красивыми темно-зелеными листьями, средними междоузлиями, прочной центральной колой и плотными соцветиями, пропитанными насыщенным ароматом тропических фруктов. Во время дегустации ощущается приятный ягодный вкус, а также мощное расслабляющее воздействие, за считанные минуты снимающее усталость и нервное напряжение.
Последнее редактирование: